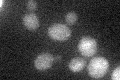
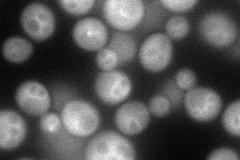
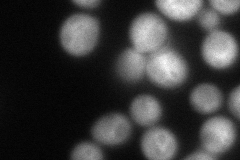
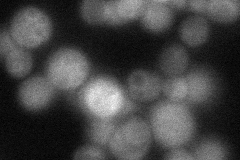
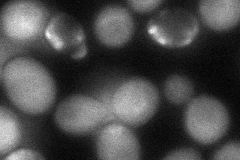

View description
Protein kinase involved in transcriptional activation of osmostress-responsive genes; regulates G1 progression, cAPK activity, nitrogen activation of the FGM pathway; involved in life span regulation; homologous to mammalian Akt/PKB
Localization:
Intensity:
Fold change:
Significance:
-
C’ GFP library in SD
cytosol19.82 -
N' NOP1pr-GFP in SD
cytosol,vacuole membrane81.309 -
N' TEF2pr-mCherry in SD
cytosol,vacuole membrane100.729 -
N' NATIVEpr-GFP in SD
cytosol,vacuole membrane41.6973 -
N' TEF2pr-VC and Cyto-VN in SD
cytosol63.8207 -
C’ GFP library in SD+DTT

cytosol22.051.11No -
C’ GFP library in SD+H2O2

cytosol19.140.96No -
C’ GFP library in Starvation Media

cytosol17.670.89No -
C’ GFP library on the background of Pup2-DaMP

cytosol -
C’ GFP library on the background of CCT mutant

cytosol19.21670.969031No
